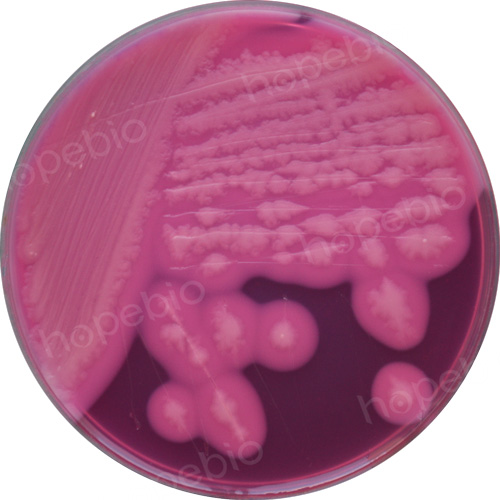
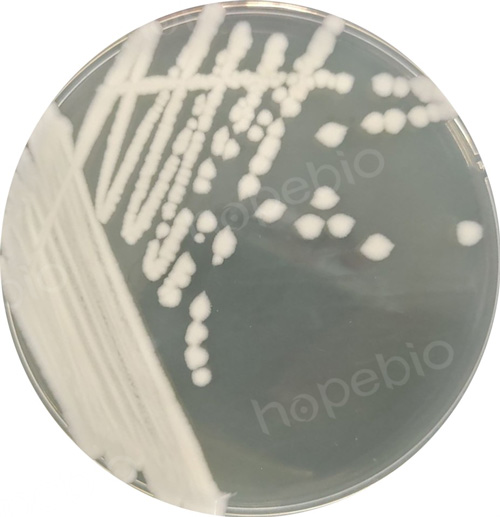
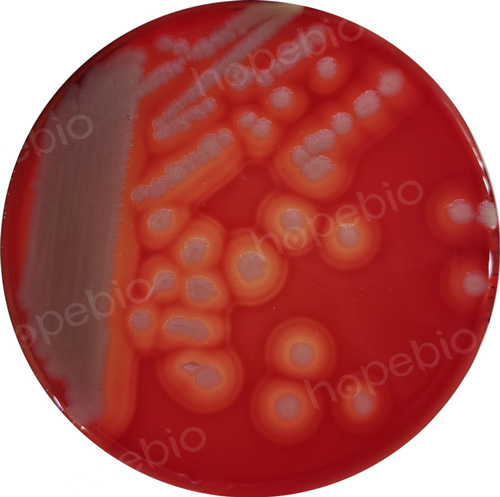
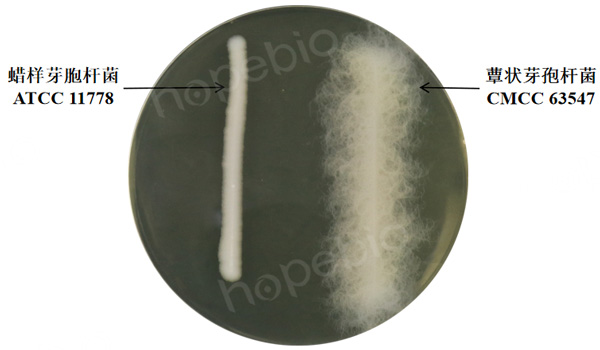
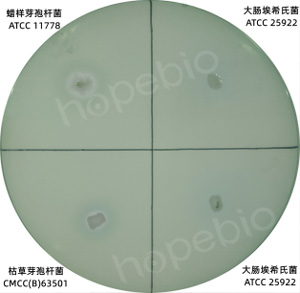

海博微信公众号
海博微信公众号
 海博天猫旗舰店
海博天猫旗舰店


 海博微信公众号
海博微信公众号
 海博天猫旗舰店
海博天猫旗舰店




一、蜡样芽孢杆菌简介
蜡样芽孢杆菌为革兰氏阳性杆菌,能形成芽孢,属于需氧芽孢杆菌属。菌体两端较平整,芽孢不大于菌体宽度,位于中央或稍偏一端,无荚膜,有周生表毛,有活动能力,能运动。本菌生长温度为25℃~37℃,最适温度为30℃~32℃。在营养琼脂平板上生长,菌落乳白色、不透明、边缘不整齐,菌落边缘呈扩散状,近看似白蜡状。在甘露醇卵磷脂多黏菌素琼脂平板上,蜡样芽孢杆菌菌落为红色(表示不发酵甘露醇),环绕粉红的晕(表示产生卵磷脂酶);在血平板上,菌落周围呈草绿色β-溶血,周围透明,菌落为浅灰色,不透明,似白色毛玻璃状;在肉汤中生长浑浊,有膜或壁环,振摇易乳化。本菌能分解麦芽糖、蔗糖、水杨苷和蕈糖,不分解乳糖、甘露醇、鼠李糖、木糖、阿拉伯糖、山梨醇,硫化氢、尿素试验阴性,卵磷脂酶试验阳性,能在24h内液化明胶,溶血、厌氧条件下发酵葡萄糖。
二、参考标准:
《GB 4789.14-2014 食品微生物学检验 蜡样芽孢杆菌检验》
三、蜡样芽孢杆菌平板计数法(第一法)
3.1 检验程序
蜡样芽孢杆菌平板计数法检验程序见图1。

图1 蜡样芽孢杆菌平板计数法检验程序
3.2 操作步骤
3.2.1 样品处理
冷冻样品应在45℃以下不超过15min或在2℃~5℃不超过18h解冻,若不能及时检验,应放于-10℃~-20℃保存;非冷冻而易腐的样品应尽可能及时检验,若不能及时检验,应置于2℃~5℃冰箱保存,24h内检验。
3.2.2 样品制备
称取样品25g,放入盛有225mL的PBS或生理盐水的无菌均质杯内,用旋转刀片式均质器以8000r/min~10000r/min均质1min~2min,或放入盛有225mL的PBS或生理盐水的无菌均质袋中,用拍击式均质器拍打1min~2min。若样品为液态,吸取25mL 样品至盛有225mL PBS或生理盐水的无菌锥形瓶(瓶内可预置适当数量的无菌玻璃珠)中,振荡混匀,作为1:10的样品匀液。
3.2.3 样品的稀释
吸取3.2.2中1:10的样品匀液1mL加到装有9mL PBS或生理盐水的稀释管中,充分混匀制成1:100的样品匀液。跟据对样品污染状况的估计,按上述操作,依次制成十倍递增系列稀释样品匀液。每递增稀释1次,换用1支1mL无菌吸管或吸头。
3.2.4 样品接种
根据对样品污染状况的估计,选择2个~3个适宜稀释度的样品匀液(液体样品可包括原液),以0.3mL、0.3mL、0.4mL接种量分别移入三块MYP琼脂平板,然后用无菌L棒涂布整个平板,注意不要触及平板边缘。使用前,如MYP琼脂平板表面有水珠,可放在25℃~50℃的培养箱里干燥,直到平板表面的水珠消失。
3.2.5 分离、培养
3.2.5.1 分离
在通常情况下,涂布后,将平板静置10min。如样液不易吸收,可将平板放在培养箱30℃±1℃培养1h,等样品匀液吸收后翻转平皿,倒置于培养箱,30℃±1℃培养24h±2h。如果菌落不典型,可继续培养24h±2h再观察。在MYP琼脂平板上,典型菌落为微粉红色(表示不发酵甘露醇),周围有白色至淡粉红色沉淀环(表示产卵磷脂酶)。培养结果如图2所示。
图2 蜡样芽孢杆菌在MYP琼脂平板上的培养结果
3.2.5.2 纯培养
从每个平板(符合3.4.1.1要求的平板)中挑取至少5个典型菌落(小于5个全选),分别划线接种于营养琼脂平板做纯培养,30℃±1℃培养24h±2h,进行确证实验。在营养琼脂平板上,典型菌落为灰白色,偶有黄绿色,不透明,表面粗糙似毛玻璃状或融蜡状,边缘常呈扩展状,直径为4mm~10mm。培养结果如图3所示。
图3 蜡样芽孢杆菌在营养琼脂平板上的培养结果
3.3 确定鉴定
3.3.1 染色镜检
挑取纯培养的单个菌落,革兰氏染色镜检。蜡样芽孢杆菌为革兰氏阳性芽孢杆菌,大小为(1μm~1.3μm)×(3μm~5μm),芽孢呈椭圆形位于菌体中央或偏端,不膨大于菌体,菌体两端较平整,多呈短链或长链状排列。染色结果如图4所示。

图4 蜡样芽孢杆菌革兰氏染色结果
3.3.2 生化鉴定
3.3.2.1 概述
挑取纯培养的单个菌落,进行过氧化氢酶试验、动力试验、硝酸盐还原试验、酪蛋白分解试验、溶菌酶耐性试验、V-P试验、葡萄糖利用(厌氧)试验、根状生长试验、溶血试验、蛋白质毒素结晶试验。蜡样芽孢杆菌生化特征与其他芽孢杆菌的区别见表1。
表1 蜡样芽孢杆菌生化特征与其他芽孢杆菌的区别
|
项目 |
蜡样芽孢杆菌 Bacillus cereus |
苏云金芽孢杆菌 Bacillus thuringiensis |
蕈状芽孢杆菌 Bacillus mycoides |
炭疽芽孢杆菌 Bacillus anthracis |
巨大芽孢杆菌 Bacillus megaterium |
|
革兰氏染色 |
+ |
+ |
+ |
+ |
+ |
|
过氧化氢酶 |
+ |
+ |
+ |
+ |
+ |
|
动力 |
+/- |
+/- |
- |
- |
+/- |
|
硝酸盐还原 |
+ |
+/- |
+ |
+ |
-/+ |
|
酪蛋白分解 |
+ |
+ |
+/- |
-/+ |
+/- |
|
溶菌酶耐性 |
+ |
+ |
+ |
+ |
- |
|
卵黄反应 |
+ |
+ |
+ |
+ |
- |
|
葡萄糖利用 (厌氧) |
+ |
+ |
+ |
+ |
- |
|
V-P试验 |
+ |
+ |
+ |
+ |
- |
|
甘露醇产酸 |
- |
- |
- |
- |
+ |
|
溶血(羊红细胞) |
+ |
+ |
+ |
-/+ |
- |
|
根状生长 |
- |
- |
+ |
- |
- |
|
蛋白质毒素晶体 |
- |
+ |
- |
- |
- |
|
注:+表示90%~100%的菌株阳性;-表示90%~100%的菌株阴性;+/-表示大多数的菌株阳性;-/+表示大多数的菌株阴性 |
|||||
3.3.2.2 动力试验
用接种针挑取培养物穿刺接种于动力培养基中,30°C培养24h。有动力的蜡样芽孢杆菌应沿穿刺线呈扩散生长,而蕈状芽孢杆菌常呈“绒毛状”生长。也可用悬滴法检查。培养结果如图5所示。

图5 动力试验结果
3.3.2.3 溶血试验
挑取纯培养的单个可疑菌落接种于TSSB琼脂平板上,30°C±1℃培养24h±2h。蜡样芽孢杆菌菌落为浅灰色,不透明,似白色毛玻璃状,有草绿色溶血环或完全溶血环。苏云金芽孢杆菌和蕈状芽孢杆菌呈现弱的溶血现象,而多数炭疽芽孢杆菌为不溶血,巨大芽孢杆菌为不溶血。培养结果如图6所示。
图6 蜡样芽孢杆菌在TSSB琼脂平板上的培养结果
3.3.2.4 根状生长试验
挑取单个可疑菌落按间隔2cm~3cm左右距离划平行直线于经室温干燥1d~2d的营养琼脂平板上,30°C±1℃培养24h~48h,不能超过72h。用蜡样芽孢杆菌和蕈状芽孢杆菌标准株作为对照进行同步试验。蕈状芽孢杆菌呈根状生长的特征。蜡样芽孢杆菌菌株呈粗糙山谷状生长的特征。结果如图7所示。
图7 根状生长试验结果
3.3.2.5 溶菌酶耐性试验
用接种环取纯菌悬液一环,接种于溶菌酶肉汤中,36°C±1°C培养24h。蜡样芽孢杆菌在本培养基(含0.001%溶菌酶)中能生长。如出现阴性反应,应继续培养24h。巨大芽孢杆菌不生长。结果如图8所示。

图8 溶菌酶耐性试验结果
3.3.2.6 蛋白质毒素结晶试验
挑取纯培养的单个可疑菌落接种于硫酸锰营养琼脂平板上,30°C±1°C培养24h±2h,并于室温放置3d~4d,挑取培养物少许于载玻片上,滴加蒸馏水混匀并涂成薄膜。经自然干燥,微火固定后,加甲醇作用30s后倾去,再通过火焰干燥,于载玻片上滴满0.5%碱性复红,放火焰上加热(微见蒸气,勿使染液沸腾)持续1min~2min,移去火焰,再更换染色液再次加温染色30s,倾去染液用洁净自来水彻底清洗、晾干后镜检。观察有无游离芽孢(浅红色)和染成深红色的菱形蛋白结晶体。如发现游离芽孢形成的不丰富,应再将培养物置室温2d~3d后进行检查。除苏云金芽孢杆菌外,其他芽孢杆菌不产生蛋白结晶体。
3.3.2.7 其他生化鉴定结果结果如图9和图10所示。

图9 过氧化氢酶试验、硝酸盐还原试验、葡萄糖利用试验、V-P试验、甘露醇产酸试验结果
图10 酪蛋白分解试验结果
3.3.3 生化分型(选做项目)
根据对柠檬酸盐利用、硝酸盐还原、淀粉水解、V-P试验反应、明胶液化试验,将蜡样芽孢杆菌分成不同生化型别,见表2。
表2 蜡样芽孢杆菌生化分型试验

图11 柠檬酸盐利用试验、淀粉水解试验、明胶液化试验结果
3.3.4 补充说明
在进行蜡样芽胞杆菌的生化鉴定时,也可使用蜡样芽胞杆菌生化鉴定条对其生化反应进行判断,蜡样芽胞杆菌生化鉴定条中包含了所有蜡样芽胞杆菌生化鉴定所需培养基,方便快捷高效。鉴定条结果如图12所示,“+”表示实验结果力阳性,“-”表示实验结果为阴性。

图12 蜡样芽胞杆菌生化鉴定条结果
3.4 结果计算
3.4.1 典型菌落计数和确认
3.4.1.1 选择有典型蜡样芽孢杆菌菌落的平板,且同一稀释度3个平板所有菌落数合计在20CFU~200CFU之间的平板,计数典型菌落数。如果出现a)~f)现象按3.4.2.1中公式(1)计算,如果出现g)现象则按3.4.2.2中公式(2)计算;
a)只有一个稀释度的平板菌落数在20CFU~200CFU之间且有典型菌落,计数该稀释度平板上的典型菌落;
b)2个连续稀释度的平板菌落数均在20CFU~200CFU之间,但只有一个稀释度的平板有典型菌落,应计数该稀释度平板上的典型菌落;
c)所有稀释度的平板菌落数均小于20CFU且有典型菌落,应计数最低稀释度平板上的典型菌落;
d)某一稀释度的平板菌落数大于200CFU且有典型菌落,但下一稀释度平板上没有典型菌落,应计数该稀释度平板上的典型菌落;
e)所有稀释度的平板菌落数均大于200CFU且有典型菌落,应计数最高稀释度平板上的典型菌落;
f)所有稀释度的平板菌落数均不在20CFU~200CFU之间且有典型菌落,其中一部分小于20CFU或大于200CFU时,应计数最接近20CFU或200CFU的稀释度平板上的典型菌落。
g)2个连续稀释度的平板菌落数均在20CFU~200CFU之间且均有典型菌落。
3.4.1.2 从每个平板中至少挑取5个典型菌落(小于5个全选),划线接种于营养琼脂平板做纯培养,30°C±1℃培养24h±2h。
3.4.2 计算公式
3.4.2.1 菌落计算公式(1)

式中:
T——样品中蜡样芽孢杆菌菌落数;
A——某一稀释度蜡样芽孢杆菌典型菌落的总数;
B——鉴定结果为蜡样芽孢杆菌的菌落数;
C——用于蜡样芽孢杆菌鉴定的菌落数;
d——稀释因子。
3.4.2.2 菌落计算公式(2)

式中:
T——样品中蜡样芽孢杆菌菌落数;
A1——第一稀释度(低稀释倍数)蜡样芽孢杆菌典型菌落的总数;
A2——第二稀释度(高稀释倍数)蜡样芽孢杆菌典型菌落的总数;
B1——第一稀释度(低稀释倍数)鉴定结果为蜡样芽孢杆菌的菌落数;
B2——第二稀释度(高稀释倍数)鉴定结果为蜡样芽孢杆菌的菌落数;
C1——第一稀释度(低稀释倍数)用于蜡样芽孢杆菌鉴定的菌落数;
C2——第二稀释度(高稀释倍数)用于蜡样芽孢杆菌鉴定的菌落数;
1.1——计算系数(如果第二稀释度蜡样芽孢杆菌鉴定结果为0,计算系数采用1);
d——稀释因子(第一稀释度)。
3.5 结果与报告
3.5.1 根据MYP平板上蜡样芽孢杆菌的典型菌落数,按3.4中公式(1)、公式(2)计算,报告每g(mL)样品中蜡样芽孢杆菌菌数,以CFU/g(mL)表示;如T值为0,则以小于1乘以最低稀释倍数报告。
3.5.2 必要时报告蜡样芽孢杆菌生化分型结果。
四、蜡样芽孢杆菌MPN计数法(第二法)
4.1 检验程序
蜡样芽孢杆菌MPN计数法检验程序见图13。

图13 蜡样芽孢杆菌MPN计数法检验程序
4.2 操作步骤
4.2.1 样品处理
同3.2.1。
4.2.2 样品制备
同3.2.2。
4.2.3 样品的稀释
同3.2.3。
4.2.4 样品接种
取3个适宜连续稀释度的样品匀液(液体样品可包括原液),接种于10mL胰酪胨大豆多黏菌素肉汤中,每一稀释度接种3管,每管接种1mL(如果接种量需要超过1mL,则用双料胰酪胨大豆多黏菌素肉汤)。于30°C±1℃培养48h±2h。培养结果如图14所示。

图14 胰酪胨大豆多黏菌素肉汤培养结果
4.2.5 培养
用接种环从各管中分别移取1环,划线接种到MYP琼脂平板上,30°C±1°C培养24h±2h。如果菌落不典型,可继续培养24h±2h再观察。
4.2.6 确定鉴定
从每个平板选取5个典型菌落(小于5个全选),划线接种于营养琼脂平板做纯培养,30°C±1°C培养24h±2h,进行确证实验,见3.3。
4.3 结果与报告
根据证实为蜡样芽孢杆菌阳性的试管管数,查MPN检索表(见附录B),报告每g(mL)样品中蜡样芽孢杆菌的最可能数,以MPN/g(mL)表示。
相关标准:
注:本文属海博生物原创,未经允许不得转载。
上一篇:空肠弯曲菌检验方法及结果判断
下一篇:柠檬酸杆菌的检验方法及结果判断



